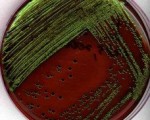

Staphylococcus – Mannitol Salt Agar Plate
Mannitol salt agar (MSA) is a differential and selective media. It is selective because its high salt concentration (7.5 %) inhibits the growth of most bacteria. However, Staphylococcus ...
Eosin methylene blue agar (EMB)
Eosin methylene blue agar (EMB) is a selective and differential medium used to isolate fecal coliforms. Eosin Y and methylene blue are pH indicator dyes which combine to form a dark ...


